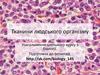
Тканини людського організму

Похожие презентации:
Тканини. Поняття гістогенез
1. Т К А Н И Н И
Тканина - це система організму, яка складається із клітинта їх похідних (гістологічних елементів), що сформувалися
у філогенезі, і виконує специфічні функції.
В утворенні тканин беруть участь клітини, надклітинні
комплекси
структури
(симпласти,
(еритроцити,
синцитії)
і
постклітинні
кератиноцити),
а
також
міжклітинна речовина (волокна і основна аморфна
речовина). При цьому кожна тканина відрізняється
певним складом перерахованих елементів.
2. ПОНЯТТЯ ГІСТОГЕНЕЗ
Гістогенез – розвиток або утворення тканин. В основі гістогенезу лежитьпроцес
диференціювання
клітин,
що
приводить
до
їх
спеціалізації.
Спеціалізація клітин виражається в появі у них специфічних ознак і, як
наслідок, у виконанні ними певних функцій.
Ембріональний гістогенез – процес виникнення спеціалізованих тканин із
мало диференційованого клітинного матеріалу ембріональних зачатків, який
відбувається протягом ембріонального розвитку організму. Ембріональні
зачатки є джерелами розвитку тканин і органів в онтогенезі, вони представлені
групами більш або менш диференційованих клітин (міжклітинної речовини
зачатки не мають). Гістогенез супроводжується розмноженням і ростом клітин,
їх переміщенням - міграцією, диференціюванням клітин і їх похідних,
міжклітинними і міжтканинними взаємодіями а також відмиранням клітин.
3. ЕТАПИ ЕМБРІОГЕНЕЗУ
ЗаплідненняУтворення синкаріону
Зигота (1-кл. зародок)
Тотіпотентна
Стадія 2-х
бластомерів
Стадія 4-х
бластомерів
Морула
Бластоциста
Дроблення. Бластула. Перехід до полі- та уніпотентності.
4. Гаструляція Утворення 3 зародкових листків - зачатків тканин
ГаструляціяУтворення 3 зародкових листків зачатків тканин
ЕКТОДЕРМА
ЕНТОДЕРМА
МЕЗОДЕРМА
В результаті комітування (це стійка репресія (пригнічення) одних і
дерепресія (активація) інших генів) клітини стають детерміновановані.
Детерміновані клітини реалізуючи програму розвитку змінюють
морфологію та функції. Такі події визначаються як диференціація. Отже,
диференціація - це послідовні зміни структури і функції клітини, які
обумовлені генетичною програмою розвитку і призводять до утворення
високоспеціалізованих клітин.
5.
Зигота є тотіпотентною, тобто здатна давати початок будь-якійклітині. Така здатність зберігається до стадії 4-8 бластомерів. Далі
відбувається перехід від тотіпопотентності до полі- та уніпотентності,
що означає поступове обмеження можливих напрямків розвитку клітин.
Цей феномен називається комітуванням. Механізм комітування – це
стійка репресія (пригнічення) одних і дерепресія (активація) інших генів.
На певній стадії комітування призводить до того, що у клітин
залишається тільки один шлях розвитку: така клітина називається
детермінованою.
Детермінована клітина реалізуючи програму розвитку змінює
морфологію та функції. Такі події визначаються як диференціація.
Отже, диференціація - це послідовні зміни структури і функції клітини,
які обумовлені генетичною програмою розвитку і призводять до
утворення високоспеціалізованих клітин.
Сукупність клітин, які послідовно розвиваються від одного типу
стовбурових клітин до зрілої спеціалізованої клітини має назву
диферону, або гістогенетичного ряду.
Тканина – це система організму, яка виникла в еволюції,
складається із одного або декількох диферонів клітин і їх похідних і
виконує специфічні функції завдяки сукупній діяльності всіх її елементів.
6. КЛАСИФІКАЦІЯ ТКАНИН
термін “тканина” запропоновано анг. вч. Н.Грю (1671) для рослин,у 1801 р. фр.вч. Біш – для тварин;
нім. вчені (1857-59 рр.) Ф.Лейдіг, Г.Келікер поділили всі тканини на 4
види: епітеліальна, сполучна, нервова, мязова
Сучасна класифікація розрізняє:
I. Е п і те л і а л ь н і тк а н и н и
II.Т к а н и н и в н у т р і ш н ь о г о с е р е д о в и щ а
III. М ’ я з о в і тк а н и н и
IV. Н е р в о в а т к а н и н а
7. Різни види тканин під мікроскопом
8. ЕПІТЕЛІАЛЬНІ ТКАНИНИ
ЕПІТЕЛІАЛЬНІ Т К А Н И Н ИРозрізняють покривний та залозистий епітелій.
Класифікація покривного епітелію. Розрізняють різні типи епітеліїв
за кількістю клітинних шарів (один чи багато) та за формою клітин. Ось
тому покривний епітелій поділяють на одно- та багатошаровий.
Класифікація залозистого епітелію. Він утворює в організмі екзо- та
ендокринні залози, що виробляють відповідно секрети та гормони.
Загальні принципи організації:
- епітелії утворюються з усіх трьох зародкових листків;
- епітеліальні тканини утворюють неперервний/і шар/и клітин;
- епітеліоцити є полярними, особливо виражена ця ознака для покривного епітелію;
- епітелій завжди лежить на базальній мембрані;
- маркерами епітеліїв є білки цитокератини;
- кровоносні та лімфатичні судини в епітелії відсутні;
- епітелій іннервований;
- однією з характерних ознак покривного епітелію є висока регенераційна здатність.
9. Класифікація епітеліїв за походженням
ДжерелоТип епітелію
Ектодерма
Епідермальний
Ентодерма
Ентеродермальний
(ентодермальний)
Мезодерма
Целонефродермальний
Нервова трубка Епендимогліальний
Мезенхіма
Ангіодермальний
Приклади
Епітелій шкіри, ротової
порожнини, стравоходу,
рогівки ока, піхви,
респіраторного відділу
легень.
Сальні, слинні, потові,
молочні залози,
аденогіпофіз, щитовидна
та паращитовидна залози
Епітелій шлунку,
тонкої та майже всієї
товстої кишки, паренхіма
печінки та підшлункової
залози
Епітелій серозних
оболонок, канальців
нирок, сім’явиносних проток, матки
Епітелій порожнин мозку епендима шлуночків мозку
та спинномозкового
каналу
Ендотелій судин
Будова епітелію
Багатошаровий
зроговілий,
незроговілий
Одношаровий
призматичний
Одношаровий
плоский;
кубічний,
призматичний
Одношаровий
Одношаровий
плоский
10. ПОКРИВНИЙ ЕПІТЕЛІЙ
Одношаровий (одно- та багаторядний) епітелійБагатошаровий (зроговілий, незроговілий, перехідний) епітелій
11. Класифікація покривних епітеліїв
ІІ. БагатошаровийІ. Одношаровий
Однорядний
Плоский
Кубічний
Призматичний
Необлямований
Облямований
Багаторядний
Зроговілий Незроговілий Перехідний
Призматичний
війчастий
Плоский
(миготливий)
Плоский
Кубічний
12. УЗАГАЛЬНЕНА БУДОВА ЕПІТЕЛІОЦИТА
13. ВИДИ МІЖКЛІТИННИХ КОНТАКТІВ У СКЛАДІ ЕПІТЕЛІЮ
14. Будова базальної мембрани епітеліоцитів
Б уд о в а б а з а л ь н о ї м е м б р а н ие п і те л і о ц и т і в
15. Будова базальної мембрани між епітеліоцитами (ниркові клубочки, легеневі альвеоли) та ендотеліоцитами
Б уд о в а б а з а л ь н о ї м е м б р а н и м і же п і те л і о ц и т а м и ( н и р к о в і к л уб о ч к и ,
л е г е н е в і а л ь в е о л и ) та е н д о те л і о ц и т а м и
Світла пластинка
Темна пластинка
Базальна
мембрана
Світла пластинка
16. Одношаровий плоский епітелій Мезотелій
Вистеляє серозні оболонкі (очеревина). Має мезодермальнепоходження.
17. Одношаровий плоский епітелій ЕНДОТЕЛІЙ КРОВОНОСНИХ СУДИН
Базальнамембрана
Ендотелій має вигляд сплющеного шару клітин з витягнутими ядрами. Ендотелій бере участь в обміні речовин та газів
між кров’ю та тканинами організму.
18. Одношаровий плоский епітелій (задня поверхня рогівки ока)
19. Одношаровий циліндрічний та кубічний епітелій канальців нирки
12
просвіт
3
Позначення: 1) епітеліоцит; 2) ядро; 3) сполучна тканина
під епітелієм з кровоносними судинами та нервами
20. ЕПІТЕЛІЙ КАНАЛЬЦІВ НИРКИ
21. Одношаровий багаторядний епітелій ВІЙЧАСТИЙ ЕПІТЕЛІЙ ТРАХЕЇ
Вистилає верхні дихальні шляхи у хребетних тварин, убезхребетних - поверхню тіла чи кишечник. До його
складу входять різні типи клітин: війчасті,
келихоподібні, та вставні (проміжні).
22. ОДНОШАРОВИЙ БАГАТОРЯДНИЙ ЕПІТЕЛІЙ КИШЕЧНИКА АСКАРИДИ
1 – базальна мембрана;2 – війки у складі
щіткової облямівки
23. ПОВЕРХНЯ ТОНКОГО КИШЕЧНИКА
Поверхня тонкого кишечника утворює складочки – ворсинки, що вистелені одношаровим циліндричнимепітелієм, та заглиблення - ліберкюнові крипти (залози)
24. Одношаровий циліндричний епітелій тонкого кишечника
Вистилає поверхню кишечника, що утворює численні ворсинки ікрипти, тобто пальцеподібні вирости і заглиблення.
25. Ліберкюнові крипти тонкого кишечника (залози)
Типи клітин: 1. Циліндричні епітеліоцити; 2. Стовбурові клітини;3. Клітини Панета (лізоцим); 4. Бокалоподібні епітеліоцити; 5. Ендо-
криноцити (секретин, глюкагон, холецистокінин, соматостатин) та інші.
26. Електронограма поверхні одношарового циліндрічного епітелію з мікроворсинками
Позначення: 1 – ядро; 2 – облямівка з мікроворсинок;3 - лімфоцит
27. Одношаровий циліндричний епітелій жовчного міхура
Циліндричні епітеліоцити мають мікроворсинки тавиконують всмоктувальну функцію
28. БАГАТОШАРОВИЙ ЕПІТЕЛІЙ
ЗроговілийНезроговілий
Перехідний
29. БАГАТОШАРОВИЙ НЕЗРОГОВІЛИЙ ЕПІТЕЛІЙ РОГІВКА ОКА
Розрізняють три шари: 1 – базальний;2- проміжний(шипуватий);3– поверхневий.
30. БАГАТОШАРОВИЙ НЕЗРОГОВІЛИЙ ЕПІТЕЛІЙ ПІХВИ
31. Багатошаровий зроговілий епітелій Епідерміс шкіри (роговий шар тонкий – справа, товстий - зліва)
Роговий шарВін складений з різних за своєю структурою та властивостями п’яти
шарів: базального, шипуватого, зернистого, блискучого, рогового.
Останній є мертвим шаром плоских рогових лусочок, які постійно
злущуються.
32.
33. БАГАТОШАРОВИЙ ЗРОГОВІЛИЙ ЕПІТЕЛІЙ Епідерміс шкіри (п'ять шарів)
Роговий шар•Роговий шар найкраще виражений у тих ділянках тіла, що піддаються
тертю (долоні рук, підошви ніг). Роговий шар складається з великої
кількості рядів плоских мертвих рогових лусочок. Між лусочками
знаходиться цементуюча речовина багата ліпідами (цераміди та інш.).
34. Деталі будови деяких шарів епідермісу шкіри
Шипуватий, зернистий,блискучий, роговий
шари
Шипуватий шар: кератиноцити з'єднані короткими відростками
35. МЕЛАНОЦИТИ у ростковому шарі епідермісу шкіри
36. Перехідний епітелій сечового міхура
Чорна стрілочка вказує на подвійні ядра у поверхневих епітеліоцитах; синя стрілочка – лімфоцитиПерехідний епітелій (товстий шар) у розслабленому стані, коли сечовий
міхур порожній
37. базальний та покривний шари (стан розслаблення)
ПЕРЕХІДНИЙ ЕПІТЕЛІЙСЕЧОВОГО МІХУРА (УРОТЕЛІЙ )
БАЗАЛЬНИЙ ТА ПОКРИВНИЙ ШАРИ
(СТАН РОЗСЛАБЛЕННЯ)
38. Будова плазмолеми поверхневих клітин перехідного епітелію
Б уд о в а п л а з м о л е м иповерхневих клітин перехідного епітелію
Г н у ч к а ділянка
П л а с т и н к и складаються з
внутрішньомембраннних
білкових частинок, кожна з яких
утворена шістьма субодиницями
Мікрофіламенти
Цитоплазма
Пластинка
Г н у ч к а ділянка
Мікрофіламенти
Цитоплазма
Складка






































 Биология
Биология